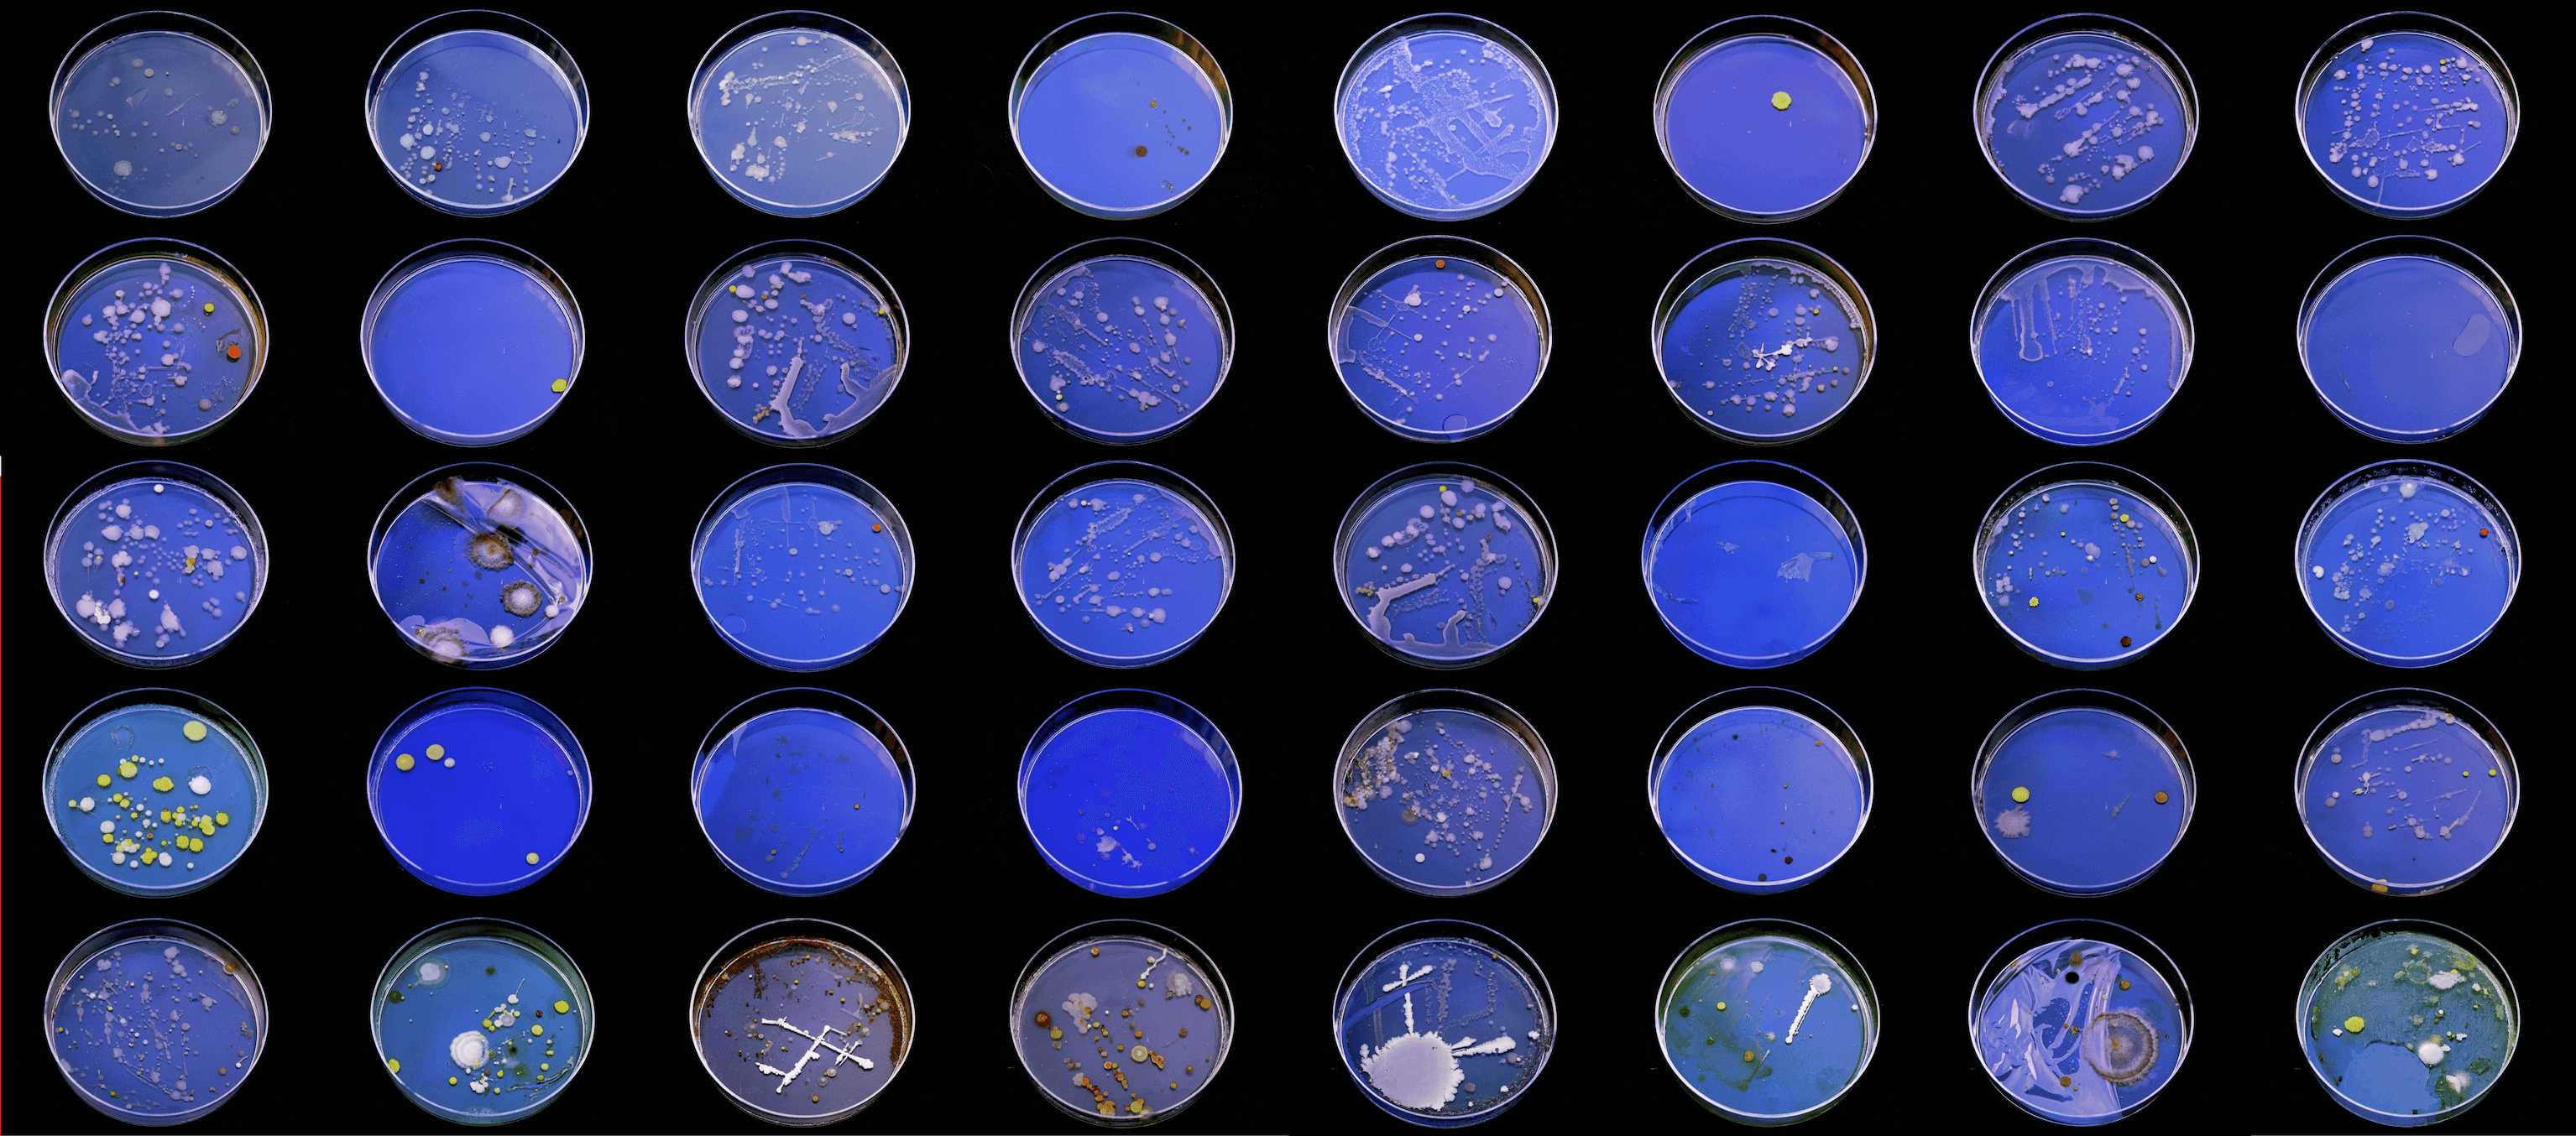
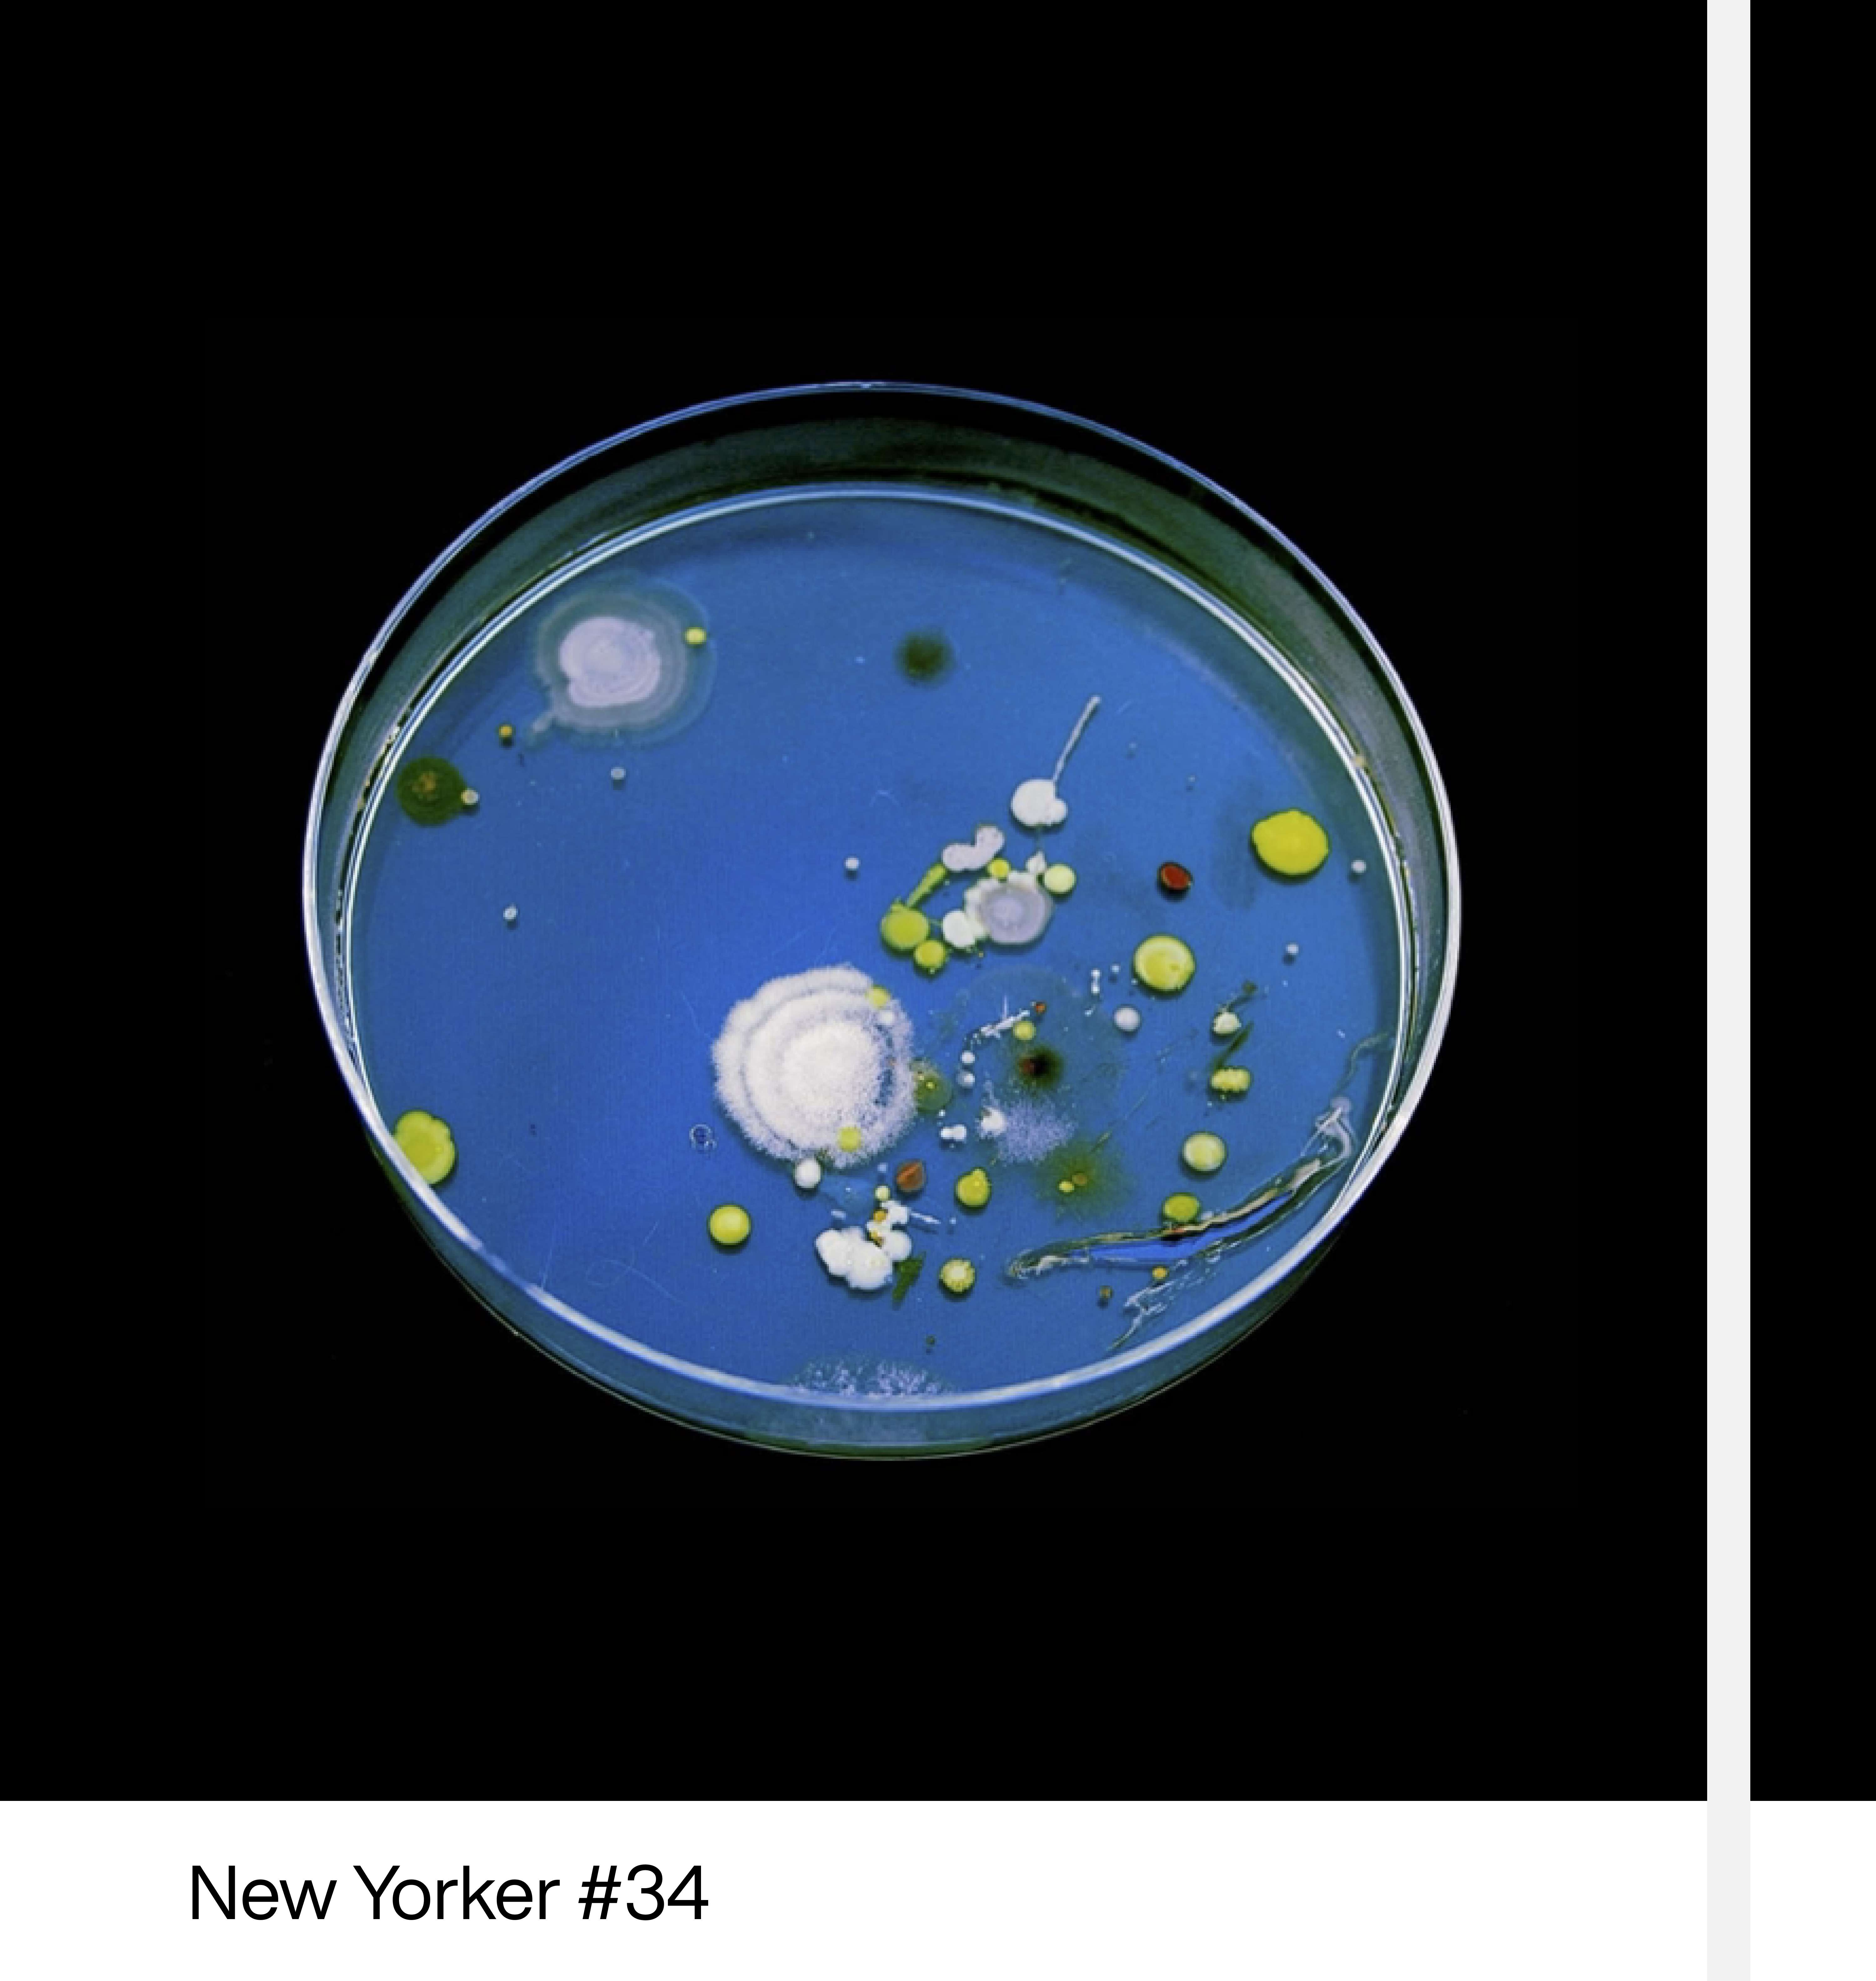
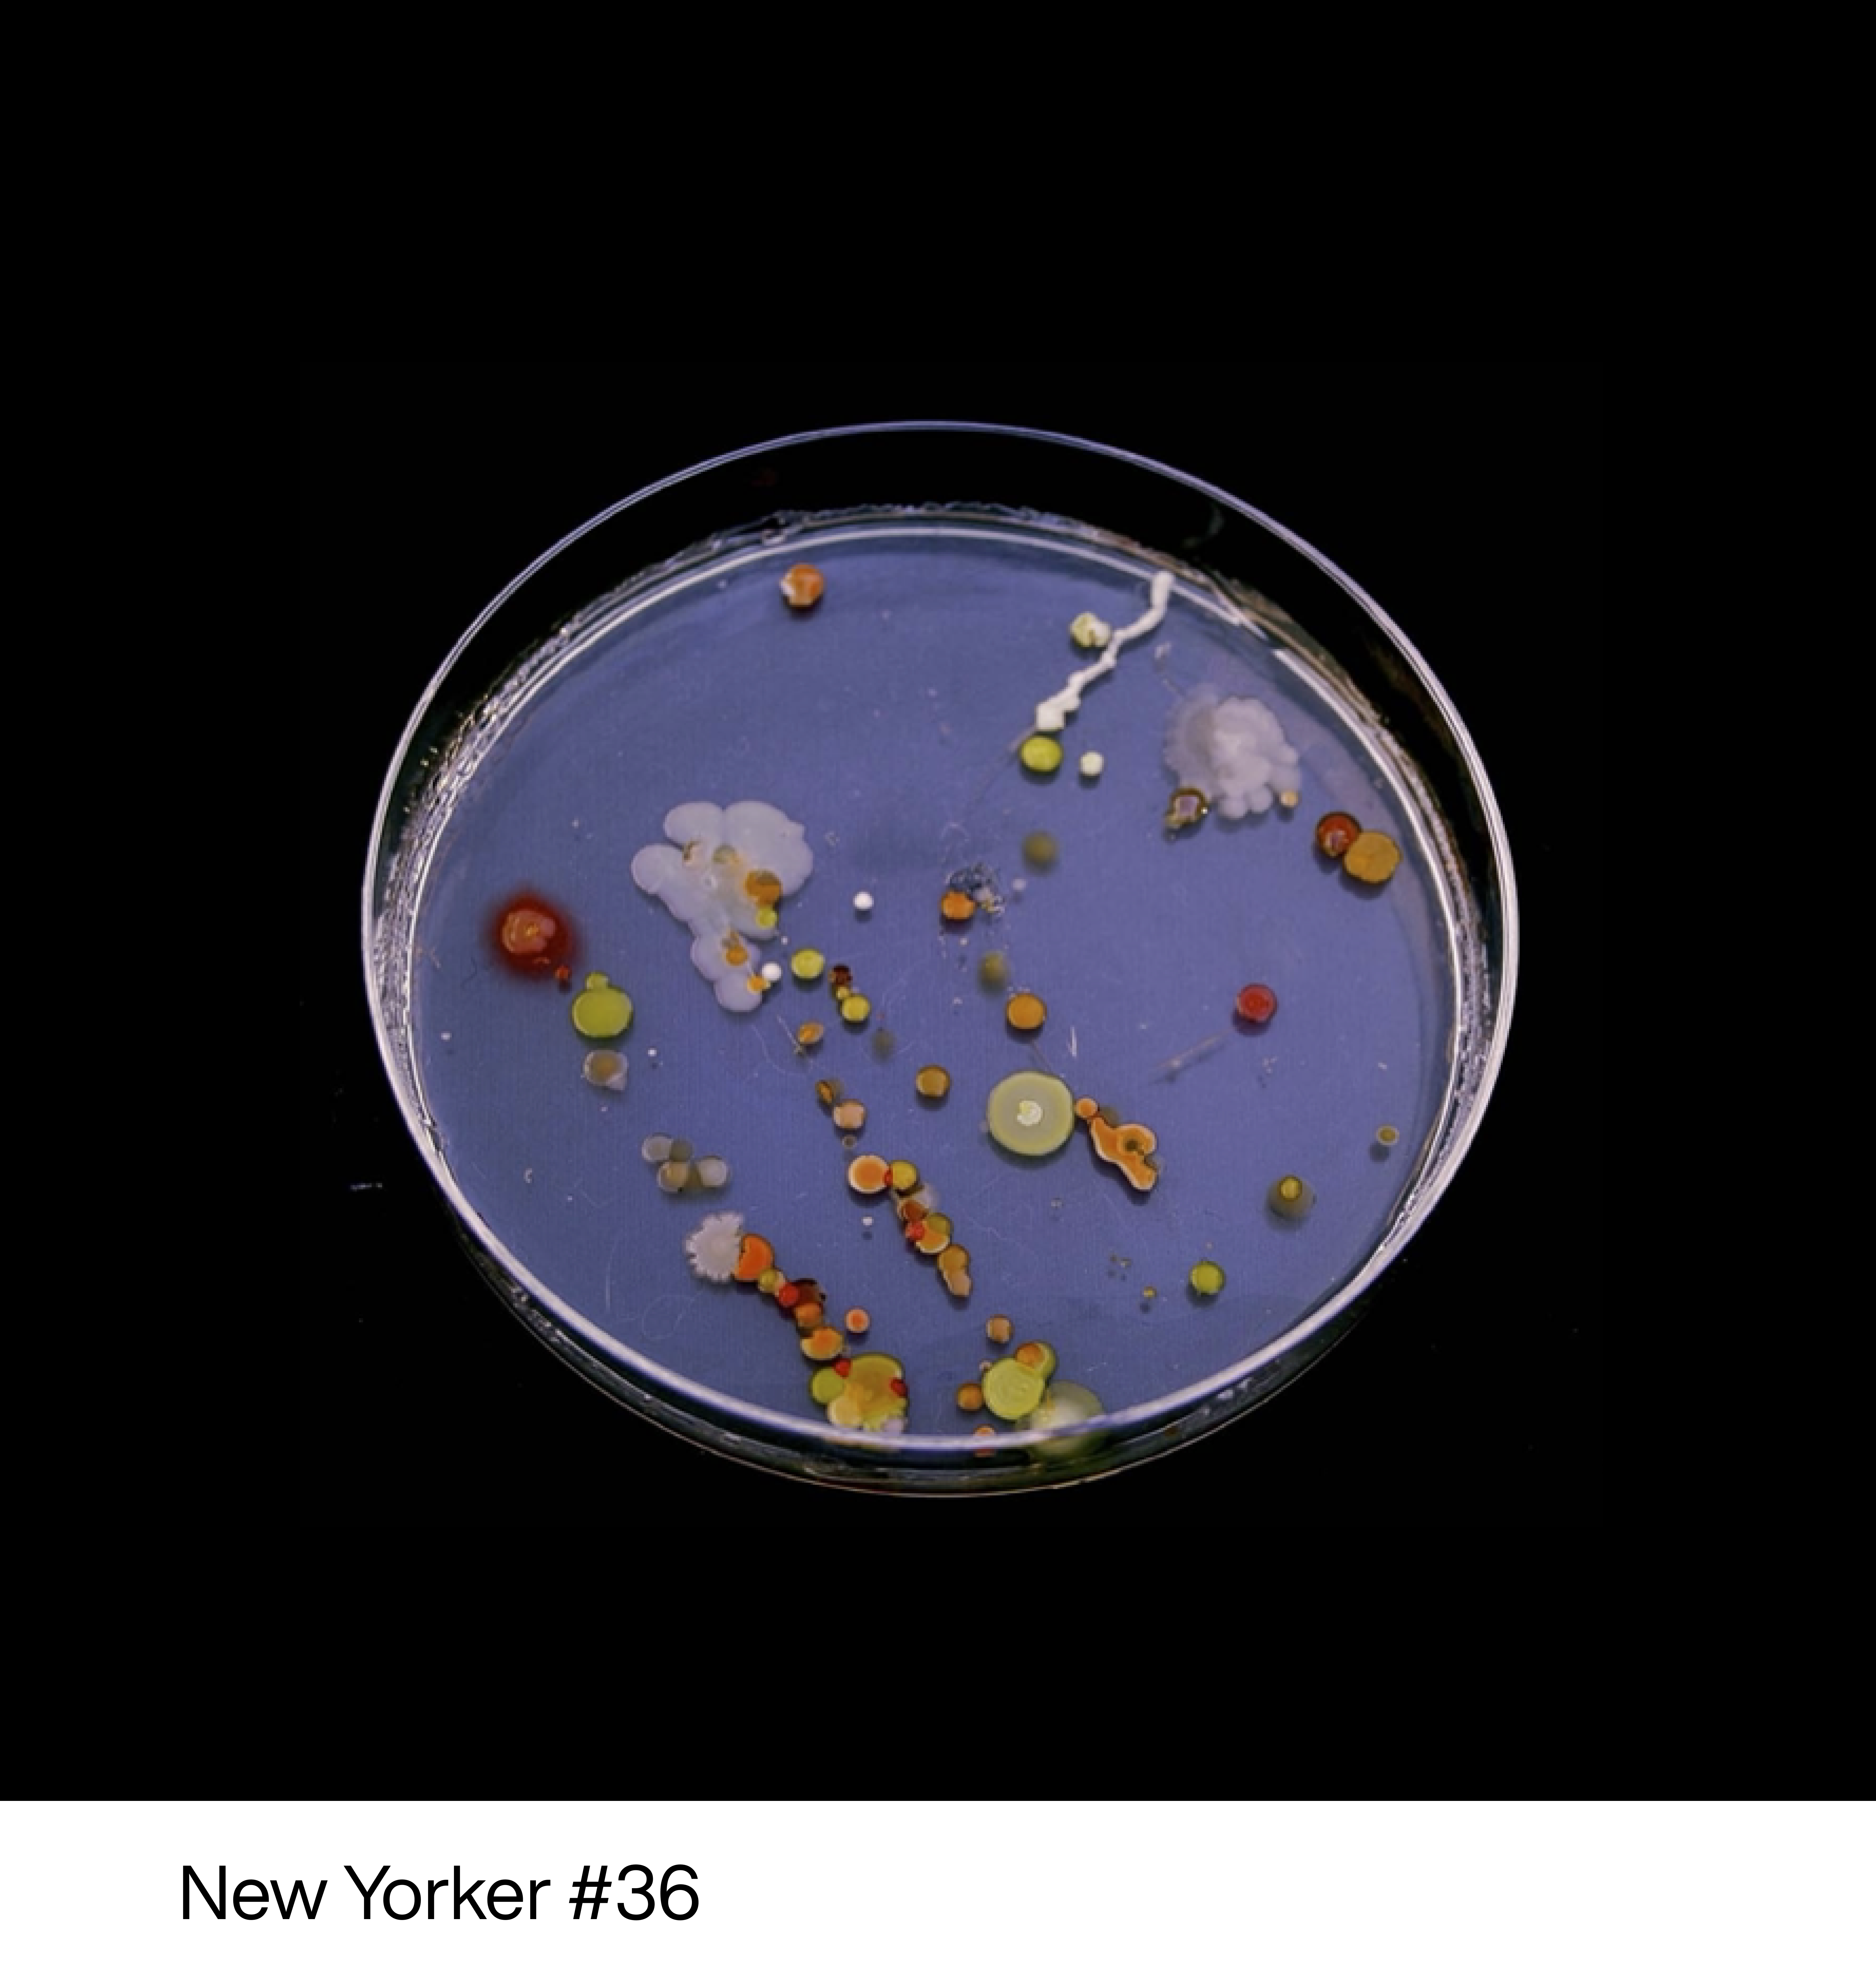

2009
An Urban Diagnosis
Role
Creator
In 2009, I decided to transition from being a genetic engineer to a designer. At that time, I did not have a portfolio of work to submit to Parsons for admission. As I was thinking about what to do about it, I got the idea of showing my biology background and my curiosity as a designer in a way that is artistic and the project High Five was born.
Receiving a high five or giving a high five is an experience that we would define uplifting. Considering that humans are electrochemical beings, I hypothesized that the act of high fiving might result in an exchange of energy and perhaps a part of it is established by the passage of microorganisms from one hand to another.
To explore this process I've used agar petri dishes as canvases, cotton swabs as my paint brush and sampled each high five interaction between me and 40 New Yorkers during the blizzard in 2009.
The project, while being far from a scientific proof of my hypothesis, created results that portrayed how nature can paint its own artwork.